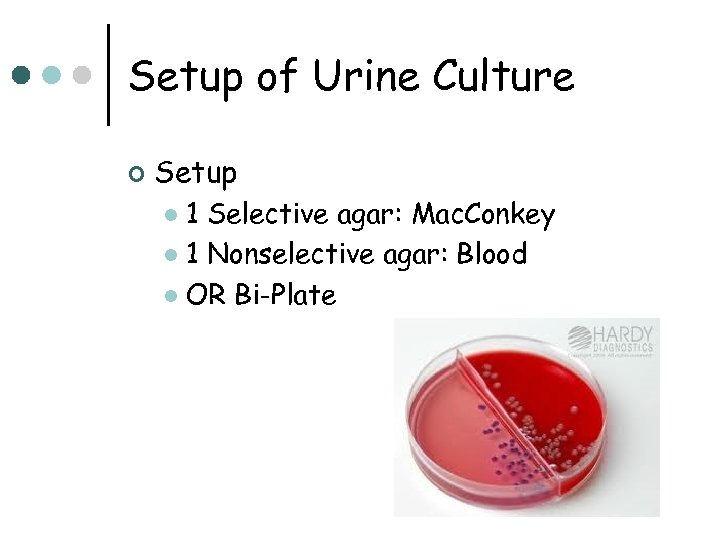
Setup of Urine Culture ¢ Setup 1 Selective agar: Mac. Conkey l 1 Nonselective

a7d496e3c6601c901aad1097479e93ce.ppt
- Количество слайдов: 28

Urinary Tract Infections MLAB 2534 –Microbiology Keri Brophy-Martinez

Definitions ¢ ¢ ¢ UTI = Urinary Tract Infection l Spectrum of diseases caused by microbial invasion of the genitourinary tract Upper UT includes renal parenchyma (pyelonephritis) and ureters (ureteritis) l Symptoms include: fever, flank pain & tenderness Lower UT includes bladder (cystitis), urethra (urethritis), and, in males, the prostrate (prostatitis) l ¢ Symptoms include: pain on urination, increased frequency, urgency, suprapubic tenderness Bacteriuria = presence of bacteria in urine; may be symptomatic or asymptomatic

Anatomy of the Urinary Tract

Urinary System ¢ ¢ Resistant to colonization and infection Characteristics of urine Hyperosmolarity l Low p. H l Very dilute urine fails to grow most bacteria l Men have prostatic fluid that is inhibitory l Flow has a washing effect l

Risk Factors: Age ¢ ¢ ¢ Infants l Boys have higher incidence rates due to uncircumcision Pre-school age l Girls infected more than boys l Most renal damage due to UTI at this age School-age children l Girls more prone to develop UTI upon sexual activity

Risk Factors: Age ¢ Adults to 65 l Low incidence unless genital-urinary abnormalities

Risk Factors: Age ¢ Over age 65 l UTIs increase dramatically in both genders l Atypical presentation • Fever, delirium, failure to thrive l l Males • Prostate changes & increased catherization • Neuromuscular changes Females • Fecal soiling & increased catherization • Neuromuscular changes • Bladder prolapse

Risk Factors: Other ¢ Institutionalized care l Increase in UTIs • Instrumentation/catherization • Genital-urinary tract abnormalities Pregnancy ¢ Renal transplant ¢

Risk Factors: Other ¢ Urinary conditions High ammonia concentration l Lowered p. H l Decreased blood flow in renal medulla l l Results in: • Reduced chemotaxis of WBCs • Reduced bactericidal activity of WBCs

Clinical Signs and Symptoms ¢ Infants and children < 2 years age l ¢ Children > 2 years l l ¢ Nonspecific symptoms: failure to thrive, vomiting, lethargy, fever Likely to have localized symptoms: Dysuria, frequency, abdominal or flank pain Adults with lower UT infections l Dysuria, frequency, urgency, and sometimes suprapubic tenderness

Clinical Signs and Symptoms (cont’d) ¢ Adults with Upper UTIs l ¢ Especially those acute pyelonephritis, include LUTI symptoms along with flank pain and tenderness and fever AGN (Acute Glomerulonephritis) l Results from immune response to S. pyogenes (Group A) infections, either respiratory or pyodermal • Edema around eyes • Hematuria • RBC and WBC casts

Pathogenesis of UTIs l Three access routes • Ascending (most significant) • Usually seen in females since ureter is shorter • Descending • Also referred to as Hematogenous/Blood-borne • Occurs as a result of bacteremia • Less than 5% of UTI’s • Lymphatic • Increased pressure on bladder causes a redirect of lymph fluid to kidney • Infection dependent on size of the bacteria, strength of the bacteria present, and how strong the body's defense mechanisms are at the time. • Very rare

Flora of Normal Voided Urine ¢ Staphylococcus epidermidis l ¢ Predominant Streptococci Alpha l Nonhemolytic l Lactobacillus species ¢ Diphtheroids ¢ Yeast ¢

Microbial Agents of UTIs

Specimen Collection ¢ ¢ Need to collect specimen to prevent normal vaginal, perianal, and urethral flora Mid-stream clean catch – if self collected, patient needs GOOD instructions Catheterized- sample must come from port NOT bag Suprapubic aspiration ( only for anaerobic culture)

Specimen Collection (cont’d) ¢ ¢ Additives – even with additive, time from collection to processing should not exceed 24 hours l Grey top culture tubes( sodium borate) keep sample integrity for up to 48 hours Transport l If not processed or preserved, urine should be cultured within 2 hours l If refrigerated, urine can be held for 24 hours

Preculture Screening ¢ Manual screening: Routine Urinalysis l Chemical screening • Leukocyte Esterase and Nitrate on urine dipstick l Urine microscopic • 5 to 10 WBC/hpf is upper limit of normal • Presence of bacteria ¢ ¢ Automated methods – expensive, except in large volume labs Gram stains generally not performed on urines

Causes for Rejection ¢ ¢ Inadequate method of collection or transport Labeling incomplete l ¢ ¢ ¢ name, source, acc # etc. Insufficient volume Fecal contamination 24 hour urines, pooled urines, and Foley catheter tips must be rejected for culture
Setup of Urine Culture ¢ Setup 1 Selective agar: Mac. Conkey l 1 Nonselective agar: Blood l OR Bi-Plate l

Urine Culture Procedure ¢ ¢ ¢ Inoculation using either a 0. 001 ml(x 1000) OR a 0. 01 ml (x 100) loop onto selective/nonselective media, such as BAP and MAC Dip calibrated loop into well-mixed urine. Quickly make a single streak down the middle of the BAP with the loop containing urine Streak back and forth across the plate perpendicular to the original inoculum, this creates a “lawn” With the same calibrated loop, do the same with the MAC plate Incubate at 35 o. C for 24 -48 hours

Urine Streaking Technique

Interpretation of Urine Cultures ¢ Is there growth? l If no growth: • At 24 hours: • Preliminary report: no growth at 24 hours • Reincubate plates • At 48 hours: • Final report: no growth at 48 hours • Discard plates

Interpretation of Urine Cultures ¢ If there is growth, what media has it grown on? BAP only: rules out the enteric GNR’s, colonies may be GPC, GPR, GNDC l BAP and MAC: most likely an enteric GNR or Pseudomonas. If multiple colony types, a gram stain must be done. l

Interpretation of Urine Cultures ¢ How many colony types are growing? l l l Specimen with ≥ three organisms is probably contamination and should not be identified unless specifically requested by physician One or two pathogens ≥ 100, 000 CFU/ml should be identified and sensitivities done One or two pathogens ≥ 100 CFU/ml should be identified only if clinical situation warrants or specimen is catheterized or suprapubic aspiration

Determining the CFU Count the numbers of colonies of the plate ¢ Multiply that number by the dilution factor of the loop ¢

Test YOUR Understanding A clean catch urine is collected from a pregnant patient with symptoms of urinary tract infection. The urine is inoculated onto blood and Mac. Conkey agar with a 0. 001 loop. After 24 hour incubation, 72 colonies grew on the blood plate. ¢ What is the colony count? ¢

Interpretation of Urine Cultures ¢ Things to consider in UTI’s Colony count of pure or predominant organism l Measurement of pyuria l Presence or absence of symptoms l

References ¢ ¢ ¢ Engelkirk, P. , & Duben-Engelkirk, J. (2008). Laboratory Diagnosis of Infectious Diseases: Essentials of Diagnostic Microbiology. Baltimore, MD: Lippincott Williams and Wilkins. https: //catalog. hardydiagnostics. com/cp_prod/Cat. Nav. aspx? oid=7405&prod oid=J 116 Mahon, C. R. , Lehman, D. C. , & Manuselis, G. (2011). Textbook of Diagnostic Microbiology (4 th ed. ). Maryland Heights, MO: Saunders.
a7d496e3c6601c901aad1097479e93ce.ppt